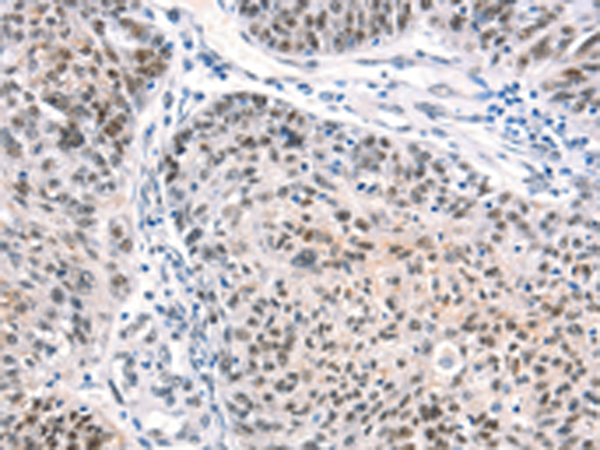
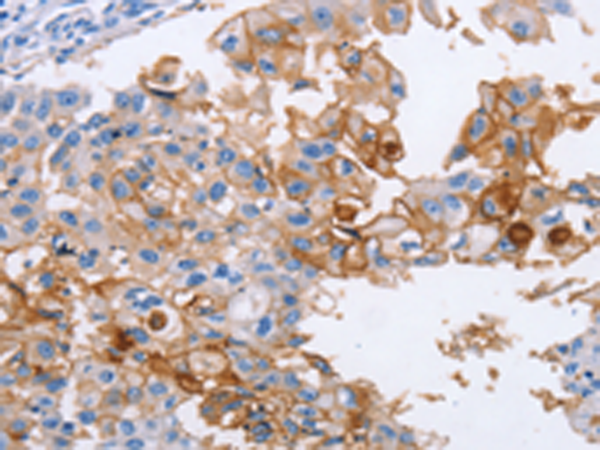

-
分类: 科研抗体货号: P11692别名:应用: WB,IHC反应种属: Human, Mouse, Rat
-
分类: 科研抗体货号: P11673别名: ICH; POREN2应用: WB,IHC反应种属: Human, Mouse
-
分类: 科研抗体货号: P11646别名: CD56; NCAM; MSK39应用: WB,IHC反应种属: Human, Mouse, Rat
-
分类: 科研抗体货号: P11690别名: ESO1; CT6.1; LAGE-2; LAGE2A; NY-ESO-1应用: IHC反应种属: Human
-
分类: 科研抗体货号: P11672别名: CMG1; CCDC2; CMG-1应用: IHC反应种属: Human
-
分类: 科研抗体货号: P11645别名: BB2; CD54; P3.58应用: WB,IHC反应种属: Human
-
分类: 科研抗体货号: P11689别名: PPP1R24应用: IHC反应种属: Human, Mouse
-
分类: 科研抗体货号: P11671别名: CCA4; AYGRP; c-MAF; CTRCT21应用: WB,IHC反应种属: Human, Mouse, Rat
-
分类: 科研抗体货号: P11643别名: IAP; OA3; MER6应用: WB,IHC反应种属: Human
-
分类: 科研抗体货号: P11688别名: AII; AVP; FCU; MWS; FCAS; CIAS1; NALP3; C1orf7; CLR1.1; PYPAF1; AGTAVPRL应用: IHC反应种属: Human, Mouse

鄂公网安备42018502007531号
鄂公网安备42018502007531号

